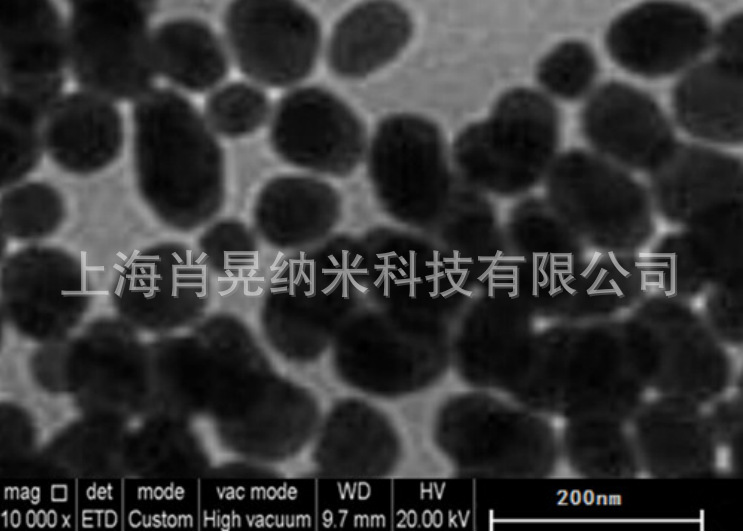

|





| 产地 | 上海 |
| 品牌 | 肖晃纳米 |
| 货号 | XH-La2O3-50 |
| 用途 | 用于压电材料、光转换农用薄膜 |
| 包装规格 | 100g/500g/1kg/5kg |
| CAS编号 | |
| 纯度 | 99.9-99.999% |
| 是否进口 | 否 |
产品介绍:
产品特点:
1、产品纯度高,粒径小,分布均匀,比表面积大,高表面活性,松装密度低;
2、微溶于水,易溶于酸而生成相应的盐类。
产品参数:
| 产品归类 | 货号 | 平均粒径 | 纯度(%) | 形貌 | 颜色 |
| 纳米级 | XH-La2O3-50 | 50nm | >99.9 | 球形 | 白色 |
| 纳米级 | XH-La2O3-80 | 80nm | >99.9 | 球形 | 白色 |
| 亚微米级 | XH-La2O3-500 | 500nm | >99.9 | 不规则 | 白色 |
| 亚微米级 | XH-La2O3-800 | 800nm | >99.9 | 不规则 | 白色 |
| 微米级 | XH-La2O3-001 | 1um | >99.9 | 不规则 | 白色 |
| 微米级 | XH-La2O3-003 | 3um | >99.9 | 不规则 | 白色 |
| 本公司可根据客户要求提供不同粒径和纯度的微纳米粉体定制生产 | |||||
产品应用:
1、纳米氧化镧应用于压电材料,增大产品的压电系数,提高产品的电能转化率;
2、纳米氧化镧用于制造高折射光学纤维板、各种合金材料;
3、纳米氧化镧用来制备有机化工产品的催化剂、中和汽车尾气催化剂;纳米氧化镧可以有效的催化吸收药的热分解,潜在的提高推进剂的燃速,是一种很有前景的催化剂;
4、纳米氧化镧应用于光转换农用薄膜,利用纳米氧化镧的光电转换效率高,有效利用微弱光源,节约能源损失;
5、纳米氧化镧应用于电铸电极材料,添加0.2%-0.5%的纳米氧化镧,可以有效提高电铸电极材料的抗电蚀能力,降低电极损耗;
6、纳米氧化镧应用于发光材料(兰粉)、贮氢材料、激光材料。
包装储存:
本品为充惰气塑料袋包装,密封保存于干燥、阴凉的环境中,不宜暴露空气中,防受潮发生氧化团聚,影响分散性能和使用效果;包装数量可以根据客户要求提供,分装。

返回顶部